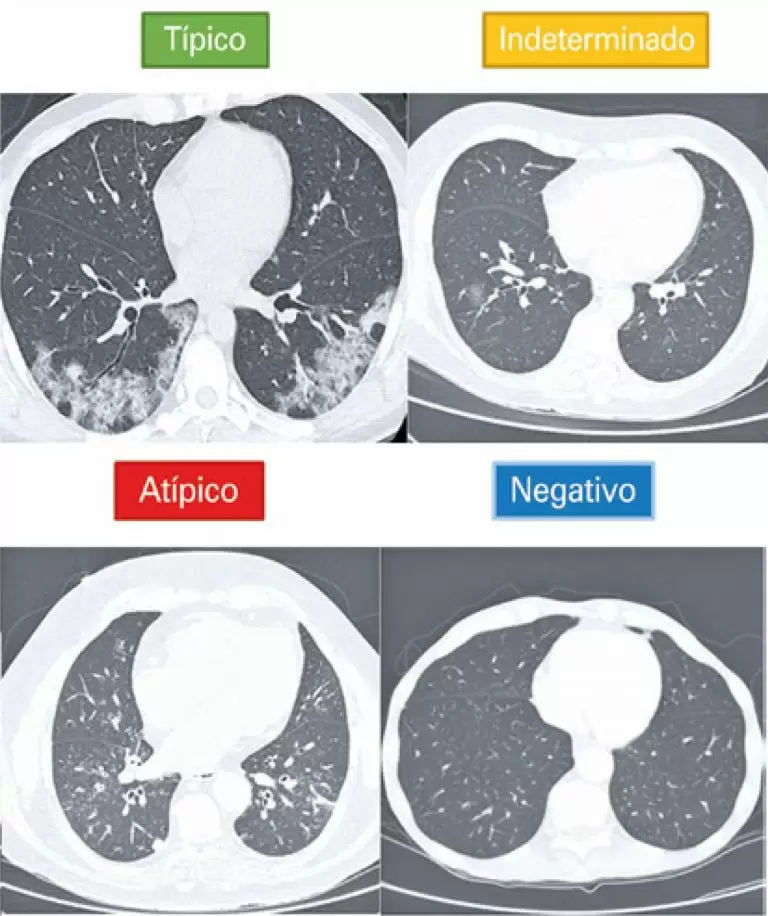

einstein (São Paulo). 26/out/2021;19:eAO6363.
Tomografia computadorizada de tórax no diagnóstico de COVID-19 em pacientes com resultado falso-negativo na RT-PCR
DOI: 10.31744/einstein_journal/2021AO6363
RESUMO
Objetivo
Avaliar o papel da tomografia computadorizada de tórax em pacientes com COVID-19 que apresentaram reação em cadeia da polimerase via transcriptase reversa (RT-PCR) inicial falsamente negativa.
Métodos
Estudo retrospectivo de centro único que avaliou 39 pacientes com RT-PCR negativa para COVID-19, submetidos à tomografia computadorizada de tórax e que tiveram diagnóstico final clínico ou serológico de COVID-19. A classificação tomográfica visual foi avaliada de acordo com o Consenso da Radiological Society of North America e o software desenvolvido com inteligência artificial para detecção automática de achados e estimativa de probabilidade de COVID-19.
Resultados
Na análise tomográfica visual, somente um deles (3%) apresentou tomografia computadorizada classificada como tendo resultado negativo, 69% foram classificados como típicos e 28% como indeterminados. Na avaliação com uso de software, somente quatro (cerca de 10%) tiveram probabilidade de COVID-19 <25%.
Conclusão
A tomografia computadorizada pode desempenhar papel importante no manejo de casos suspeitos de COVID-19 com RT-PCR inicialmente negativa, principalmente levando-se em consideração os pacientes que estão fora da janela ideal para coleta de amostra para RT-PCR.
4.930